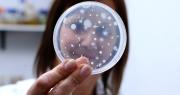
La Provincia financiará once proyectos de innovación de la UNLP pensados para asistir a las PyMEs bonaerenses

Sociedad
13 de diciembre de 2025 Página 3
Pocas horas antes de la final del Torneo Clausura, tres micros que transportaban hinchas de Estudiantes de La Plata -que se enfrentará contra Racing este sábado a las 21- hacia Santiago del Estero chocaron en la ruta 8, a la altura de la localidad de Solís. De acuerdo a las... + más

- Doctor Bühler, ¿cuáles son los aspectos más relevantes de la reforma laboral propuesta por el gobierno? Reforma laboral de Milei Reforma laboral en duda: Bullrich y la carrera contrarreloj en el Senado... + más

Bariloche pone en marcha un Taller de Arqueología Accesible destinado a personas con discapacidad visual. Será a partir de febrero y no hay antecedentes de una propuesta similar que intente acercar el conocimiento arqueológico y el patrimonio histórico de la región de forma... + más

San Juan volvió a vivir un momento de dolor este viernes por la mañana, cuando Juan Cabrera, de 72 años, perdió la vida en un accidente en Ruta Nacional 40 y Calle 9, en Pocito. Cabrera era un vendedor de verduras que se había convertido en un rostro conocido y querido de... + más

Loto Plus y el sorteo 3839 de la noche de este sábado 13 de diciembre de 2025, con un pozo de varios miles de millones de pesos. Seguí en minutouno.com los sorteos del Loto Plus, el juego millonario de la Ciudad de Buenos Aires. Informate más Loto Plus: control en vivo los... + más
El Servicio Meteorológico Nacional ha emitido un alerta amarilla por viento para la provincia de Neuquén. Este alerta está vigente desde el 12 de diciembre a las 03:00 hasta el 13 de diciembre a las 08:59. Se prevén vientos del sector oeste con velocidades entre 50 y 70... + más
En las últimas semanas la empresa tecnológica de Mark Zuckerberg, Meta, eliminó o restringió cuentas de proveedores de acceso al aborto, de contenido queer y de organizaciones ligadas a la salud reproductiva. A modo de respuesta, los activistas cuestionaron a una de las... + más
Alerta amarilla por tormentas en la provincia de Córdoba desde el 13 de diciembre a las 09:00 hasta el 14 de diciembre a las 02:59. El Servicio Meteorológico Nacional advierte que el área será afectada por tormentas de variada intensidad, algunas de ellas puntualmente... + más

El Servicio Meteorológico Nacional (SMN) emitió alerta amarilla por viento en Neuquén y Río Negro para este sábado 13. Las nuevas zonas afectadas y los peores horarios. Lee También La alerta por viento en Neuquén y Río Negro se extendió hasta el sábado: zonas afectadas... + más

Con las fiestas y el aguinaldo cada vez más cerca, las tiendas digitales empiezan a llenarse de ofertas y descuentos relámpago en celulares y diferentes productos tecnológicos. Por este motivo, muchas marcas buscan captar a quienes quieren renovar el teléfono antes de fin de... + más

CABA La Ciudad presenta la restauración de la Floralis Genérica con un evento cultural abierto al público La tradicional escultura de Recoleta vuelve a lucirse tras una compleja intervención técnica. Este sábado, de 13 a 21, habrá música en vivo, gastronomía, arte y una... + más
Estudiantes de La Plata informó que, “tres micros que trasladaban hinchas de la delegación del Club colisionaron entre sí sobre la Ruta 8, a la altura de Solís”.Los micros se dirigían a la ciudad de Santiago del Estero trasladando hinchas a la final del torneo de AFA... + más

El Servicio Meteorológico Nacional (SMN) renovó la alerta amarilla por viento para este sábado 13 de diciembre. A pesar de esto, se descartó que el temporal alcance la región del Alto Valle, aunque el pronóstico indica que sí se sentirán fuertes ráfagas durante el día.... + más

El Ministerio de Salud de la Provincia de Neuquén anunció una gran iniciativa para promover la vacunación en toda la provincia: La Noche de las Vacunas. El evento se desarrollará el jueves 19 de diciembre con el fin de completar esquemas de inmunización de cara a las... + más
Aniversario de Neuquén: las mejores fotos del desfile | LMNeuquen
Resultados elecciones 2025 en Neuquén: así fueron los votos en cada ciudad | LMNeuquen

SAGITARIO (Desde el 23 de Noviembre hasta el 21 de Diciembre)SUERTE NUMERICA: 71-50-11. Sufrirá una pérdida de carácter económico si no toma las medidas para prevenirla. Mal intestinal. ARIES (Desde el 21 de Marzo hasta el 20 de Abril)SUERTE NUMERICA: 14-55-12. Realizará... + más

El jueves 11 de diciembre se llevó a cabo la comida de fin de año Adepa, en el Hotel Sheraton de la Ciudad de Buenos Aires. Acudieron representantes de los tres poderes del Estado, referentes de todo el arco político, líderes empresariales, académicos, diplomáticos,... + más

La mujer fue encontrada herida y ensangrentada entre pastizales; a pocos metros apareció un hombre fallecido por un disparo en la cabeza. Hoy 10:28 Ugartechi y Carlos Casares Una pareja fue encontrada muerta este viernes por la noche en la localidad de Mariano Acosta, partido... + más

La Libertad Avanza quiere el debate del presupuesto el martes, dictaminar el miércoles y el jueves ir al recinto para darle media sanción. Hoy 06:19 El lunes volverá la actividad en la Cámara de Diputados de la Nación cuando se conformen las cinco comisiones a las que... + más
El martes llegó a la Argentina el Tirzepatida, un nuevo fármaco inyectable para adelgazar. Jorge Tartaglione, quien estuvo a cargo de esa presentación en el país, visitó los estudios de LN+ y aseguró que se trata de una novedad “que revolucionó el mundo”. Además,... + más

La Cámara de Diputados de San Juan aprobó este jueves la nueva Ley de Transporte, una normativa largamente esperada que busca ordenar, modernizar y transparentar todo el sistema provincial. La norma introduce cambios estructurales, especialmente en el sector de taxis y... + más
Departamento por departamento, así fueron los resultados finales en las elecciones 2025 en San Juan: los cambios y los 0 votos en el exterior | Tiempo de San Juan
Cuáles fueron los resultados en todos los departamentos de San Juan: Capital para LLA, 6 para el oficialismo y el peronismo sumó 12 triunfos | Tiempo de San Juan
José Perrucio, un empresario oriundo de la ciudad de Cómodoro Rivadavia, Chubut, compró el famoso juego de té con el que Yiya Murano envenenó con cianuro y mató a tres amigas suyas en 1979 en la Ciudad Autónoma de Buenos Aires.A raíz del estremecedor acontecimiento... + más

Pronóstico del tiempo A qué hora llueve en CABA y el conurbano este fin de semana: alerta en el clima por tormentas El Servicio Meteorológico adelantó cómo estará el clima en la Ciudad de Buenos Aires y en el conurbano este fin de semana. 13 de diciembre, 2025 05.00... + más
La Universidad Nacional de La Plata (UNLP) recibirá fondos de la Provincia para financiar once iniciativas de innovación tecnológica seleccionadas por el Fondo de Innovación Tecnológica de la provincia de Buenos Aires (FITBA). Los proyectos forman parte de un paquete más... + más
El Servicio Meteorológico Nacional ha emitido un alerta amarilla para la provincia de Mendoza debido a viento Zonda y tormentas. El alerta por viento Zonda rige desde el 12 de diciembre a las 03:00 hasta el 13 de diciembre a las 02:59, con velocidades entre 30 y 45 km/h y... + más
Notibol. Desde 2006. Central de Noticias.
Notibol es un agregador informático de noticias y no es responsable del contenido de los enlaces a los sitios externos que generan las noticias.
Acerca de Notibol | Contacto | Política de Privacidad | Descargo de Responsabilidad